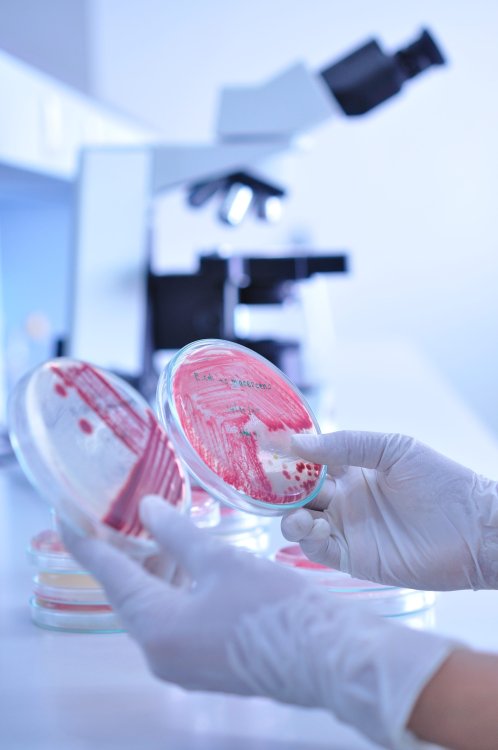
Источник ru.123rf.com

Древние произведения искусства, пережившие множество поколений, требуют особенно бережного хранения. Часто причиной их разрушения становится плесень, споры которой постоянно присутствуют в воздухе и распространяются с пылью. Ученые ФИЦ Биотехнологии РАН и ИМБ РАН совместно с другими российскими специалистами разработали антисептик нового поколения и протестировали его воздействие на микроорганизмы-деструкторы из Государственной Третьяковской галереи. Статья с результатами их многолетней работы опубликована в научном журнале Frontiers in Microbiology.
Плесневые грибы — одна из главных угроз для объектов культурного наследия и исторических артефактов. Эти микроорганизмы могут расти на самых разных поверхностях, разрушая своей грибницей красочный слой и продуцируя разнообразные пигменты. Сотрудники ФИЦ Биотехнологии РАН и Института молекулярной биологии им. В.А. Энгельгардта РАН предложили и протестировали новый состав для защиты картин от биоповреждений. В работе участвовали также специалисты Третьяковской галереи и Института общей неорганической химии им. Н.С. Курнакова РАН.
«В особенной опасности находятся древние картины и иконы, написанные темперой. Такая краска на основе яичных желтков, рыбьего клея и других органических ингредиентов — отличная питательная среда для плесневых грибов и других микроорганизмов. Однако большинство антисептиков, изначально разработанных для сельского хозяйства или медицины, зачастую не пригодны для защиты произведений искусства, поскольку могут нанести вред самим картинам или быть токсичными для посетителей и реставраторов. Мы разработали и испытали более безопасные вещества – аналоги природных аминокислот», — рассказал ведущий автор работы Александр Жгун, руководитель группы генетической инженерии грибов ФИЦ Биотехнологии РАН.
Для борьбы с микроорганизмами российские ученые синтезировали соединения, похожие на аминокислоты, занимающие ключевое место в обмене веществ и являющиеся строительными блоками для белковых молекул. Только в отличие от аминокислот в этих соединениях место карбоксильной группы (–COOH) занимает фосфорсодержащая группа. Такая группа присутствует в структуре, например, природных антибиотиков фосфомицина и фосмидомицина, которые используются в практической медицине.
«Синтезированные нами фосфоаналоги аминокислот проникают в плесневые грибы, но не в клетки млекопитающих, а правильное сочетание фосфорсодержащей группы и боковой цепи аминокислоты позволило избирательно тормозить биологические процессы, жизненно важные для грибов», — прокомментировал ключевой автор работы Алексей Хомутов, ведущий научный сотрудник ИМБ РАН.
Активность 12 фосфоаналогов аминокислот была изучена на образцах плесневых грибов из залов Третьяковской галереи, где выставляется древнерусская живопись. Среди этих микроорганизмов были представители родов Aspergillus, Penicillium, Simplicillium, Microascus, Cladosporium и Ulocladium. Некоторые из них уже показали устойчивость к традиционным антисептикам.
Все синтезированные нами фосфоаналоги аминокислот успешно подавляли рост плесневых грибов на стандартных микробиологических средах. Судя по тому, что Penicillium chrysogenum (один из самых распространенных плесневых грибов, благодаря которому был открыт пенициллин) ещё и потерял свою окраску, полученные соединения также нарушали биосинтез пигментов этого гриба.
На следующем этапе ученые внесли наиболее активные соединения в осетровый клей, который художники и реставраторы применяют для закрепления слоев краски. Такой подход традиционно использовался в древнерусской живописи. Микроорганизмы были нанесены на макеты с выкрасками осетрового клея, содержащими созданные нами и стандартные, применяемые для защиты произведений живописи, антисептики. Фосфоаналог аминокислоты метионина проявил наибольшую активность и превосходил по защитным свойствам стандартные антисептики – Катамин АБ и пентахлорофенолят натрия. При этом, по данным атомно-силовой микроскопии, новый антисептик не повреждал покрытие и не изменял спектральные характеристики выкрасок осетрового клея.
«В нашей статье впервые показано, что фосфоаналоги природных аминокислот могут быть успешно использованы для защиты произведений живописи от биоповреждений. Полученные нами соединения водорастворимы, что расширяет возможности их практического применения и отличает их от многих традиционных антисептиков», — отметил Алексей Хомутов.
«Эта разработка — итог многолетней междисциплинарной работы, в рамках которой трудились биологи, химики-синтетики, аналитики и реставраторы», — пояснил Александр Жгун.
Информация предоставлена пресс-службой ФИЦ Биотехнологии РАН
Источник фото: ru.123rf.com